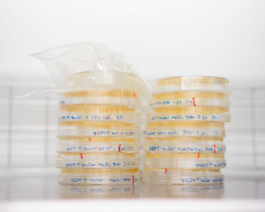
STUDIO TISSKA

Studio Tisska! Das sind Katinka Schuett und Anna Tiessen.
Seit vielen Jahren arbeiten wir mit viel Freude Seite an Seite als Fotografinnen in Berlin und Hamburg. Dabei bündeln wir unsere Kompetenzen aus Reportage und Porträtfotografie sowie der Durchführung von Werbeproduktionen. Die Arbeit als Duo ermöglicht uns ein sehr effektives und flexibles Arbeiten.
Unser Ansatz bei Studio Tisska: Wir glauben fest daran, dass die besten Bilder aus echten Momenten und authentischen Begegnungen entstehen. Wir nehmen uns die Zeit, Ihre Vision zu verstehen und Ihre Unternehmenskultur zu erfassen, um dann Bilder zu schaffen, die sowohl ästhetisch ansprechend sind, als auch Ihre Identität widerspiegeln.































































Adresse
Studio Tisska
Mahlower Straße 23
12049 Berlin
kontakt
office@studiotisska.de
+49 172 4490932
Studio Tisska! Das sind Katinka Schuett und Anna Tiessen.
Seit vielen Jahren arbeiten wir mit viel Freude Seite an Seite als Fotografinnen in Berlin und Hamburg. Dabei bündeln wir unsere Kompetenzen aus Reportage und Porträtfotografie sowie der Durchführung von Werbeproduktionen. Die Arbeit als Duo ermöglicht uns ein sehr effektives und flexibles Arbeiten.
Unser Ansatz bei Studio Tisska: Wir glauben fest daran, dass die besten Bilder aus echten Momenten und authentischen Begegnungen entstehen. Wir nehmen uns die Zeit, Ihre Vision zu verstehen und Ihre Unternehmenskultur zu erfassen, um dann Bilder zu schaffen, die sowohl ästhetisch ansprechend sind, als auch Ihre Identität widerspiegeln.

Adresse
Studio Tisska
Mahlower Straße 23
12049 Berlin
kontakt
office@studiotisska.de
+49 172 4490932
kontakt
Studio Tisska
Katinka Schuett & Anna Tiessen
office@studiotisska.de
+49 172 4490932
kontakt
Studio Tisska
Katinka Schuett & Anna Tiessen
office@studiotisska.de
+49 172 4490932